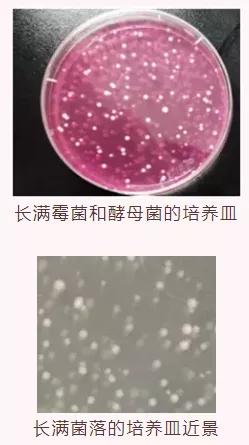

■按:建议大家在有效期内使用面膜。
许多消费者都会忽略面膜的有效期限,只要面膜没干,敷到脸上没出现皮肤问题,大家依然会继续使用。
那么过期面膜究竟有没有问题呢?对此,上海市消保委对过期面膜进行了微生物测试。

本次测试共收集了五款过期面膜,包括补水、美白、修护等功效。五款面膜的过期时间分别为:2017年7月,2020年10月,2020年12月,2021年3月,2021年5月。
由于本次测试是科普性测试且都是过期产品,与品牌无关,因此不公开具体品牌名称,检测的过程是严谨且专业的。

经过测试发现,在5款过期面膜中,有两款超标,一款是过期4年2个月的面膜,菌落总数为55000CFU/g,霉菌总数为59000CFU/g;
另一款是过期3个月的面膜,它的菌落总数大于300000CFU/g,细菌数量超过了标准的300倍。
▲注:其余致病菌未检出
根据《化妆品安全技术规范》,眼部化妆品、口唇化妆品和儿童化妆品的菌落总数不超过500CFU/g,其他普通化妆品的菌落总数不超过1000CFU/g,霉菌和酵母菌总数不超过100CFU/g。
针对以上结果,相关领域的专家表示,菌落指数超标容易导致面膜的营养成分被破坏,消费者如使用过期面膜,可能会引起细菌感染,产生过敏。因此建议大家在有效期内使用。
此外,过期面膜在上脸时会靠近眼睛等容易感染的位置,可能对皮肤造成伤害。
来源:《消费者报道》综合上海市消保委